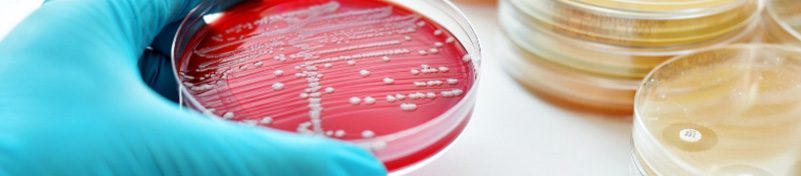

آلودگی میکروبی در محصولات آرایشی و شوینده: چالش ها و راه های کنترل آلودگی
فهرست مطالب
حفظ ایمنی و پایداری فرمولاسیونهای غیر استریل، همواره یکی از دغدغههای اصلی تولیدکنندگان صنعت است. در این میان، آلودگی میکروبی در محصولات آرایشی و بهداشتی به عنوان یک چالش جدی و حیاتی، میتواند به طور مستقیم بر کیفیت نهایی و سلامت مصرفکننده اثر بگذارد و اعتبار برند را خدشهدار کند. از آنجا که خلوص و کیفیت مواد اولیه شیمیایی نقش کلیدی در کنترل بار میکروبی و پیشگیری از فساد زودرس محصول دارد، نظارت دقیق بر زنجیره تأمین امری اجتنابناپذیر است. در این مقاله، به بررسی دقیق ریشهها و عوامل ایجاد کننده این آلودگی پرداخته و در ادامه، راهکارهای تخصصی و عملیاتی را برای حل این چالش و تضمین سلامت محصول ارائه میدهیم
آلودگی میکروبی در محصولات آرایشی و شوینده
آلودگی میکروبی میتواند در هر یک از مراحل چرخه عمر محصول رخ دهد؛ از تأمین مواد اولیه و فرایند تولید گرفته تا بستهبندی، حمل و نقل و حتی در زمان مصرف توسط مصرفکننده. مطالعات میدانی نشان دادهاند که درصد قابل توجهی از محصولات آرایشی و بهداشتی در شرایط واقعی مصرف، در معرض آلودگی قرار میگیرند. در این میان، وجود یک سیستم نگهدارنده مؤثر، همراه با پایش و کنترل منظم میکروبی، نقش کلیدی در کاهش این ریسکها و حفظ کیفیت و ایمنی محصول ایفا میکند.
مطالعه بیشتر:ترندهای تاثیرگذار بر مواد اولیه آرایشی و بهداشتی در ۲۵ سال آینده
1– مواد اولیه بی کیفیت:
کیفیت مواد اولیه تأثیر مستقیم و قابل توجهی بر بار میکروبی و ایمنی محصولات غیر استریل دارد، زیرا مواد اولیه با بار میکروبی بالا میتوانند به عنوان منبع اولیه ورود میکروارگانیسمها به محصول عمل کنند و کنترل آلودگی را دشوارتر کنند. مطالعات علمی نشان دادهاند که حتی مواد خام دارویی غیر استریل باید مطابق با حدود میکروبی تعریف شده در فارماکوپه ها (Pharmacopoeia) باشند. در برخی بررسی ها، ترکیبات طبیعی مانند عصاره های گیاهی به دلیل تماس با محیط رشد و فرآوری آبی، بار میکروبی بیشتری نسبت به مواد تصفیهشده داشتهاند و نیازمند پایش و کنترل دقیق هستند. بنابراین، انتخاب مواد اولیه با کیفیت میکروبی پایین و اجرای آزمونهای کنترل میکروبی پیش از تولید، از ارکان اساسی تضمین کیفیت و ایمنی محصولات دارویی، آرایشی و دیگر محصولات غیر استریل است.
2– آب و محیط تولید آلوده:
آب یکی از مهمترین حاملهای میکروارگانیسمها در فرایند تولید شناخته شده است، زیرا مصرف بالایی در تولید محصولات دارویی، آرایشی و شوینده دارد. استفاده از آب آلوده می تواند بار میکروبی را افزایش دهد و حتی سیستمهای نگهدارنده را ناکارآمد کند. محیط تولید نیز، بهصورت مستقیم یا غیرمستقیم، میتواند منبع آلودگی باشد، بهویژه اگر تجهیزات به درستی تمیز و ضدعفونی نشوند.
پیامدهای آلودگی میکروبی
آلودگی میکروبی میتواند تبعات زیادی برای تولیدکنندگان و مصرف کنندگان داشته باشد. این مشکل، در محصولات آرایشی میتواند باعث تحریکات پوستی، التهاب، عفونتهای چشمی یا در موارد شدید منجر به جمعآوری محصول از بازار شود.
به همین دلیل، استانداردها و دستورالعملهای معتبری مانند ISO 17516 حدود مشخصی را برای شمارش کل میکروارگانیسمها و عدم حضور برخی پاتوژنهای (Pathogen) خاص در محصولات آرایشی تعیین کردهاند تا ایمنی مصرفکننده تضمین شود.
نقش مواد نگهدارنده در کنترل آلودگی میکروبی محصولات:
محصولات غیر استریل نظیر کرمها، لوسیونها، محلولها و داروهای موضعی، به دلیل داشتن آب و ترکیبات آلی، محیطی مناسب برای رشد و تکثیر میکروارگانیسمها فراهم میکنند.
مواد نگهدارنده مؤثر ستون اساسی مقابله با آلودگی میکروبی در فرمولاسیونهای غیر استریل هستند. بدون یک سیستم نگهدارنده مناسب، محصول ممکن است به سرعت میکروبی و دچار مشکل شود. تستهای اثربخشی نگهدارنده (Preservative Efficacy Tests) بهمنظور اطمینان از توانایی سیستم نگهدارنده در مهار رشد میکروبی انجام میشود، که اهمیت ویژه ای در فرآیند تولید محصول دارند. البته میکرواورگانیسم های مختلف ممکن است، سطوح مختلفی از مقاومت را در برابر نگهدارنده ها نشان دهند، که ممکن است، تست اثر بخشی نگهدارنده ها را دچار چالش کنند.
کاهش ریسک میکروبی شدن محصول در صنعت شوینده:
اگرچه بسیاری از شویندهها به دلیل وجود ترکیبات فعال سطحی و pH نامناسب برای رشد میکروارگانیسمها، بهطور طبیعی از حساسیت کمتری نسبت به آلودگی میکروبی برخوردارند، اما محصولاتی که حاوی مقادیر قابل توجهی آب، عصارههای طبیعی یا مواد افزودنی خاص هستند، همچنان می توانند در معرض آلودگی میکروبی قرار گیرند.
– کنترل کیفیت میکروبی در تمام مراحل زنجیره تأمین:
انتخاب تأمین کنندگان مواد اولیه با سیستمهای کنترل کیفیت اثبات شده و اعتبارسنجی منظم مواد خام می تواند بار میکروبی اولیه را کاهش دهد.
– آزمون های میکروبی منظم:
اجرای آزمونهای میکروبی در مراحل مختلف فرایند تولید و پیش از عرضه به بازار، امکان شناسایی بهموقع رشد میکروبی بالقوه و انجام اقدامات اصلاحی لازم را فراهم میکند.
– طراحی فرمولاسیون مقاوم:
طراحی فرمولاسیون با pH نامناسب برای میکروبها، انتخاب نگهدارندههای متناسب، میتواند به پایداری میکروبی محصول کمک کند.
چرا “پدیده شیمی جم” شریک مطمئن تولیدکنندگان است؟
شرکت پدیده شیمی جم تولید کننده مواد اولیه شیمیایی با درک حساسیتهای صنعت دارویی و آرایشی، استانداردهای تأمین مواد اولیه را بازتعریف کرده است.
مزایای همکاری با ما:
تولید مواد اولیه در شرایط GMP: تمامی فرآیندها مطابق با اصول Good Manufacturing Practice طراحی شدهاند.
اتاق تمیز (Clean Room) و گواهینامه دارویی: با راهاندازی کلین روم و اخذ گواهینامه GMP دارویی در سال 1403، ما استانداردی فراتر از مواد اولیه معمولی را به شما ارائه میدهیم.
تستهای دقیق آزمایشگاهی: هیچ مادهای بدون پاس کردن تستهای میکروبی سختگیرانه از انبار ما خارج نمیشود.
به دنبال مواد اولیه ایمن و پایدار برای محصولات خود هستید؟ همین حالا با کارشناسان فنی ما به شماره 02188580000تماس بگیرید.
دستهبندی نوشتهها
عبارت «پوست نوزاد» بلافاصله لطافت و نرمی بینظیری را در ذهن تداعی میکند؛ اما برای متخصصان و فرمولاتورها، پشت این ظاهر ظریف، واقعیتی پیچیده و حساس نهفته است. پوست نوزاد دارای سدّ دفاعی (Skin Barrier) تکاملنیافتهای است که هنوز توان کافی برای مقابله با عوامل محیطی را ندارد و نفوذپذیری آن بسیار بالاست. دقیقاً به همین دلیل است که استانداردها و معیارهای انتخاب مواد اولیه آرایشی بهداشتی برای محصولات کودک، تفاوتهای بنیادینی با محصولات بزرگسالان دارد. یک اشتباه کوچک در گزینش این ترکیبات میتواند منجر به تحریکات شدید پوستی شود. بنابراین، فرمولاسیون ایمن نیازمند درک عمیقی از فیزیولوژی پوست است. در این مقاله، ویژگیهای پوست نوزاد، چالشهای ساخت و لیست ترکیبات مورد تایید FDA را بررسی میکنیم.
شناخت ویژگیها و حساسیتهای پوست در حال رشد نوزاد
پوست نوزاد تنها یک نسخه کوچکشده از پوست بزرگسال نیست؛ بلکه دارای تفاوتهای ساختاری و عملکردی ویژهای است که آن را نیازمند مراقبتهای خاص میکند. در ادامه سه ویژگی اصلی و چالشهای فیزیولوژیک مرتبط با آنها بررسی میشود:
-
نازک تر بودن لایهٔ شاخی (Stratum Corneum)
پوست نوزادان در مقایسه با بزرگسالان، دارای لایهٔ شاخی است که حدود ۳۰ درصد نازکتر است و فاصلهٔ بین سلولهای این لایه نیز بیشتر است.
چالشهای فیزیولوژیک پوست نوزاد:
- توان کمتر در حفظ رطوبت
- افزایش سرعت جذب و دفع آب( میتواند باعث خشکی پوست شود)
- آسیبپذیری بیشتر در برابر مواد شیمیایی و نفوذپذیری بالا نسبت به مواد موضعی، که در برخی موارد احتمال بروز حساسیت یا حتی اثرات سمی را افزایش میدهد.
-
در حال شکلگیری بودن لایه اسیدی محافظ (Acid Mantle)
غدد چربی و غدد عرق در نوزادان فعالیت کمتری دارند، بنابراین لایه اسیدی محافظ پوست هنوز بهطور کامل شکل نگرفته است. به همین دلیل است که پوست نوزاد در چند روز اول pH خنثی دارد، در حالی که pH پوست بزرگسالان بهطور طبیعی اسیدی است.
چالشهای فیزیولوژیک پوست نوزاد:
- احتمال بیشتر تماس و رشد میکروبها روی پوست
- آسیبپذیری بالاتر در برابر عفونتها و تحریکات پوستی مانند اِدرارسوختگی
- تمایل زیاد به خشکی پوست
بیشتر بخوانید: فرمولاسیون شامپو بدون سولفات
-
ملانین کمتر
پوست نوزادان مقدار بسیار کمی مواد رنگساز دارد، به همین دلیل ملانین بسیار کمتری نسبت به بزرگسالان تولید میکند.
چالش فیزیولوژیک پوست نوزاد:
- نبودِ محافظت طبیعی در برابر نور خورشید
جدول بررسی ویژگی ساختاری پوست نوزاد
|
ویژگی ساختاری پوست نوزاد |
توضیحات دقیق |
چالش فیزیولوژیک و ریسکها |
راهکار در فرمولاسیون |
|
نازک بودن لایه شاخی |
۳۰٪ نازکتر از بزرگسالان با فاصله سلولی بیشتر | نفوذپذیری بالا نسبت به مواد شیمیایی و دفع سریع آب (خشکی) | استفاده از نرمکنندههای قوی و حذف مواد سمی/حساسیتزا |
|
عدم تکامل لایه اسیدی |
فعالیت کم غدد چربی و عرق (pH خنثی در بدو تولد) | مستعد رشد میکروب، عفونت قارچی و ادرار سوختگی | تنظیم دقیق pH محصول و استفاده از ترکیبات آنتیباکتریال ملایم |
|
کمبود ملانین |
تولید ناچیز رنگدانه توسط ملانوسیتها | عدم محافظت طبیعی در برابر اشعه UV خورشید | نیاز به محافظت فیزیکی (عدم استفاده از فیلتر شیمیایی در نوزادان) |
چگونه مواد اولیه شیمیایی مناسب برای محصولات مخصوص کودک را انتخاب کنیم؟
عدم استفاده از مواد با ریسک احتمالی برای نوزادان:
بهطور طبیعی، هر مادهای که از نظر ایجاد حساسیت، آلرژی یا میزان جذب از طریق پوست روی پوست نوزاد آزمایش نشده باشد، نباید در فرمولاسیون محصولات مخصوص کودک استفاده شود. برای نمونه، مواد شوینده خیلی قوی مثل سدیم لوریل سولفات، نگهدارندههای زیاد یا خیلی قوی، مواد چربیزدا، افزودنیهای حاوی PEG و رایحهها بهتر است در محصولات کودک به کار نروند. البته این مواد ذاتاً خطرناک نیستند و لزوماً نباید از محصولات بزرگسالان حذف شوند؛ اما توصیه میشود خود این مواد و فرمولهایی که آنها را در بر دارند، پیش از استفاده روی پوست نوزاد حتماً ارزیابی و آزمایش شوند. همچنین باید توجه داشت که با وجود مفید بودن نگهدارندههای طبیعی در برخی محصولات کودک، ایمنی آنها روی پوست نوزاد همیشه بهطور کامل بررسی نشده است؛ بنابراین در استفاده از آنها نیز باید احتیاط کرد.
استفاده نرمکنندهها و عوامل حفظ رطوبت مناسب نوزاد:
پوست نوزاد برای بازگرداندن چربی و حفاظت از سد طبیعی خود به مراقبت ویژه نیاز دارد، به همین دلیل مرطوبکنندهها، عوامل نگهدارنده رطوبت و نرمکننده ها گزینههای ایدهآلی برای فرمولهای مراقبت از پوست کودک هستند. دیمتیکون بهخصوص یک ماده ایمن و بسیار مؤثر در این زمینه محسوب میشود. در واقع، سازمان غذا و داروی آمریکا (FDA) یک مونوگراف منتشر کرده که فهرستی از موادی را برای ادعاهای دارویی مرتبط با حفاظت از پوست مجاز دانسته است، از جمله:
- دیمتیکون ۱–۳۰٪
- گلیسیرین ۲۰–۴۵٪
- آلانتوئین ۰.۵–۲٪
- پترولاتوم ۳۰–۱۰۰٪
بهطور کلی، هر نرمکنندهای که بتواند از تبخیر شدید آب از پوست (TEWL) جلوگیری کند و رطوبت پوست را حفظ کند مناسب است، به شرطی که به عنوان عامل ایجاد کومدون (مسدودکننده منافذ) و حساسیت زا شناخته نشده باشد.
نکات مهم و قابل توجه در فرمولاسیون محصولات مراقبت از کودک
ساخت محصولات مراقبت از کودک نیازمند درک دقیق از مواد اولیه و تأثیرات احتمالی آنها روی پوست نوزاد است. بازار بهشدت آماده محصولاتی است که بر اساس منابع تجدیدپذیر، طبیعی یا الهامگرفته از طبیعت تولید شوند. علاوه بر این، pH محصول باید نزدیک به pH طبیعی پوست نوزاد باشد و غلظت مواد فعال و نگهدارندهها مطابق استانداردهای ایمنی تنظیم شود. انجام تستهای پوستی اختصاصی برای نوزادان قبل از عرضه محصول، تضمینکننده ایمنی و اثرگذاری محصول خواهد بود.
تستها و استانداردهای ایمنی
محصولات کودک باید مطابق استانداردهای بین المللی تولید و آزمایش شوند. انجام تستهای بالینی و آزمایشگاهی قبل از عرضه، علاوه بر اطمینان از ایمنی، به ایجاد اعتماد والدین نیز کمک میکند.
روند بازاریابی و توجه والدین
امروزه والدین بیش از پیش به منابع طبیعی و ایمنی اهمیت میدهند. محصولاتی که با ترکیبات ایمن و طبیعی تولید میشوند، اعتماد بیشتری جلب کرده و در بازار موفقتر هستند. این روند باعث شده که تولیدکنندگان، ترکیبات الهامگرفته از ورنیکس و مواد بازسازیکننده سد پوست را در فرمولاسیونهای خود به کار ببرند.
جمع بندی :
پوست نوزاد تنها یک نسخه کوچکشده از پوست بزرگسال نیست، بلکه ساختاری فیزیولوژیک با ویژگیهای منحصربهفرد دارد. نازکتر بودن ۳۰ درصدی لایه شاخی، عدم تکامل لایه اسیدی و فعالیت کم غدد چربی، این پوست را به شدت در برابر نفوذ مواد شیمیایی و از دست دادن رطوبت آسیبپذیر میکند. بنابراین، هنر فرمولاسیون محصولات کودک در انتخاب هوشمندانه مواد اولیه نهفته است؛ حذف ترکیبات پرخطر نظیر SLS و پارابنهای قوی و جایگزینی آنها با مواد ایمن و تاییدشده توسط FDA مانند دیمتیکون، گلیسیرین و پترولاتوم. در نهایت، موفقیت در این بازار در گرو تولید محصولاتی است که علاوه بر بازسازی سد دفاعی پوست، از منابع طبیعی الهام گرفته و پیش از عرضه، تمامی تستهای ایمنی و بالینی را با موفقیت پشت سر گذاشته باشند.
سوالات متداول :
۱. چرا پوست نوزاد سریعتر از بزرگسالان خشک میشود؟
زیرا لایه شاخی (Stratum Corneum) در نوزادان ۳۰ درصد نازکتر است و فاصله بین سلولهای آن بیشتر میباشد. این ساختار باعث میشود سرعت تبخیر آب از سطح پوست (TEWL) افزایش یافته و رطوبت سریعتر از دست برود.
۲. سازمان FDA چه موادی را برای محافظت از پوست نوزاد ایمن میداند؟
طبق مونوگراف FDA، موادی مانند دیمتیکون (۱ تا ۳۰٪)، گلیسیرین (۲۰ تا ۴۵٪)، آلانتوئین (۰.۵ تا ۲٪) و پترولاتوم (۳۰ تا ۱۰۰٪) برای استفاده در محصولات محافظت از پوست کودک ایمن و مؤثر هستند.
۳. چه ترکیباتی نباید در فرمولاسیون محصولات کودک استفاده شوند؟
استفاده از شویندههای قوی مانند سدیم لوریل سولفات (SLS)، نگهدارندههای قوی، مواد چربیزدای خشن، ترکیبات حاوی PEG و رایحههای آلرژیزا به دلیل نفوذپذیری بالای پوست نوزاد توصیه نمیشود.
شرکت پدیده شیمی جم تولید کننده مواد اولیه شیمیایی صنایع در ایران می باشد. جهت خرید و ثبت سفارش مواد اولیه شیمیایی با کارشناسان فروش این مرکز به شماره 02188580000 تماس بگیرید.
منبع:
مواد اولیه شیمیایی نقش کلیدی در صنایع مختلف، از جمله صنعت زیبایی و مراقبت شخصی دارند. در سالهای آینده صنعت مواد اولیه شیمیایی با تحولی عمیق روبهرو خواهد شد. افزایش نیاز به پایداری، رشد سریع زیستفناوری و توسعه زیستداروها، مسیر این صنعت را بهطور اساسی تغییر میدهد. امروز مواد اولیه تخصصی فقط بخشی از فرمولاسیون نیستند؛ بلکه به ابزارهایی برای خلق نوآوری و مزیت رقابتی تبدیل شدهاند.
پایداری: از اهداف سازمانی تا پایداری محصول:
گزارش «ریسک جهانی ۲۰۲۴» مجمع جهانی اقتصاد نشان میدهد چرا پایداری محیط زیست به یکی از مهمترین اولویتهای صنعت مواد اولیه شیمیایی تبدیل شده است. ریسک های اصلی در دهه آینده شامل کمبود منابع طبیعی، از دست رفتن تنوع زیستی و رویدادهای شدید آب و هوایی ناشی از تغییرات اقلیمی می باشند که همگی به محیط زیست مربوط می شوند.
در حال حاضر تأثیر این مشکلات، در تصمیمات خرید مصرفکنندگان قابل مشاهده است. برای نمونه، بخش قابل توجهی از مصرفکنندگان ترجیح میدهند محصولاتی پایدارتر را از شرکتهایی خریداری کنند که رفتار مسئولانه دارند و برای مقابله با تغییرات اقلیمی راه حل ارائه می دهند. این روند رو به رشد خواهد بود و بنابراین نفوذ مفهوم پایداری در تصمیم گیریهای کسب و کارهای مختلف افزایش مییابد و طی دهه های پیشرو نقش بسیار عمیقتری در شکلدهی به بخش مواد اولیه تخصصی خواهد داشت.
ادعاهای پایداری دیگر تنها به کاهش انتشار گازهای گلخانهای محدود نیستند و توجه ویژهای به منابع کربن، قابلیت تجزیهپذیری و سرنوشت نهایی محصولات خواهد شد. همچنین، روند گذار از مواد اولیه پتروشیمیایی به سمت مواد زیستی، بازیافتی و ضایعاتی با سرعت بیشتری ادامه خواهد یافت و پیشبینی می شود سهم مواد اولیه پتروشیمیایی در صنعت مواد اولیه طی ۲۵ سال آینده به طور چشمگیری کاهش یابد.
پیامد این ترندها کاملاً روشن است: مفهوم پایداری در حال باز تعریف این صنعت است. شرکتها باید در همه مراحل زنجیره تأمین، روشها و محصولات خود را بازنگری کنند تا هم اثرات زیستمحیطی کاهش یابد و هم نیازهای متنوع مشتریان و بازار آینده پاسخ داده شود.
بیشتر بخوانید: عوامل موثر بر بازار مایع ظرفشویی در سطح
بیوتکنولوژی (زیست فناوری):
بیوتکنولوژی هماکنون فرآیندهای سنتی تولید مواد اولیه را متحول کرده است و انتظار میرود این روند طی ۲۵ سال آینده نیز ادامه یابد، زیرا توجه به راهحلهای زیستفناورانه، بهویژه در حوزه داروسازی و محصولات مراقبت فردی، روزبهروز بیشتر میشود.
شخصی سازی (Persolnalization):
شخصیسازی یکی از تحولات جدید در حوزه داروسازی و مراقبتهای شخصی طی ۲۵ سال آینده خواهد بود. تصور کنید وارد فروشگاهی میشوید و محصولی کاملاً مطابق با نیازهای منحصر به فرد پوست خود دریافت میکنید. این ایده که امروز هنوز محدود و خاص است، در چند دهه آینده، بهویژه در بازارهای توسعهیافته، میتواند به طور گسترده رایج شود.
هوش مصنوعی (AI):
هوش مصنوعی در صنعت مواد اولیه به ابزاری کارآمد تبدیل شده است؛ فرآیند کشف مواد جدید را سرعت میبخشد، بهرهوری تولید را افزایش میدهد و پیشبینی تقاضا را دقیقتر میکند. با این حال، کیفیت دادهها همچنان عامل تعیین کننده در اثربخشی این فناوری است.
راهکارهای پایدار برای حفاظت از منابع و محیط زیست:
استخراج نادرست مواد اولیه باعث کمبود منابع، تخریب زیستگاه ها و کاهش تنوع زیستی میشود. گذار به سمت منابع زیستی، بازیافتی و پسماند با سرعت بیشتری ادامه دارد و انتظار میرود سهم مواد اولیه پتروشیمی در صنعت مواد آرایشی طی ۲۵ سال آینده کاهش چشمگیری داشته باشد. منابع کربن پایدار، از جمله لیگنین گیاهی و فناوریهای جذب گازهای پسماند، در کانون توجه صنعت قرار دارند.
چالشها و فرصتهای صنعت مواد اولیه در مواجهه با تغییرات جمعیتی و فرهنگی:
رشد اقتصادی در کشورهای درحال توسعه از بازارهای کشورهای توسعهیافته پیشی گرفته و آسیا، خاورمیانه و آفریقا بهعنوان منابع مهم رشد این صنعت در آینده مطرح شدهاند. این رشد عمدتاً ناشی از گسترش طبقه متوسط و روند شهرنشینی است و باعث شده محصولات مراقبت فردی در فرهنگها و بازارهای مختلف جهان نفوذ بیشتری پیدا کنند. در نتیجه، تأمین کنندگان مواد اولیه ملزماند تفاوتهای فرهنگی و قومی را در سبد محصولات خود در نظر بگیرند.
جمعیت سالمند نیز یکی از محرکهای مهم مصرف بهشمار میرود. بر اساس آمار سازمان جهانی بهداشت، تا سال ۲۰۵۰ سهم افراد بالای ۶۰ سال به ۲۲٪ خواهد رسید، در حالی که این رقم در سال ۲۰۱۵ تنها ۱۲٪ بود. افراد مسن در بازارهای توسعهیافته معمولاً درآمد قابلتصرف بیشتری دارند و مسئولیت های کمتری بر عهدهشان است، بنابراین بیشتر به خریدهای لوکس و ناگهانی تمایل نشان می دهند. همچنین با افزایش طول عمر، این افراد به دنبال محصولاتی هستند که حس سلامتی بیشتر و ظاهری جوانتر به آنها بدهد.
امروزه زیبایی در همه مراحل زندگی مترادف با تندرستی، اعتماد به نفس و عزتنفس شده است. این روند فرصتی فراهم میکند تا برای جمعیت سالمند، که سهم رو به رشدی از جمعیت جهانی را تشکیل میدهند، محصولات و تجربههای بهتری ارائه شود. همه این عوامل تأثیر چشمگیری بر صنعت مواد اولیه خواهند داشت.
بیشتر بخوانید: استراتژی فرمولاسیون برای تولید شویندههای پرطرفدار
جمعبندی: آینده در گروی مسئولیتپذیری
صنعت مواد اولیه شیمیایی در آستانه عصری جدید قرار دارد؛ عصری که در آن پایداری، نوآوریهای بیوتکنولوژیک و توجه به نیازهای شخصیسازیشده مصرفکننده، مسیر رشد را دیکته میکنند. موفقیت در این دهه مستلزم سرمایهگذاری سنگین در تحقیق و توسعه برای کشف منابع کربن پایدار (مانند لیگنین گیاهی و فناوریهای جذب گازهای پسماند) و همسویی کامل با ارزشها و خواستههای جدید بازار است. شرکتهایی که بتوانند این توازن را میان تکنولوژی و مسئولیتپذیری اجتماعی ایجاد کنند، رهبران تحولآفرین صنعت خواهند بود.